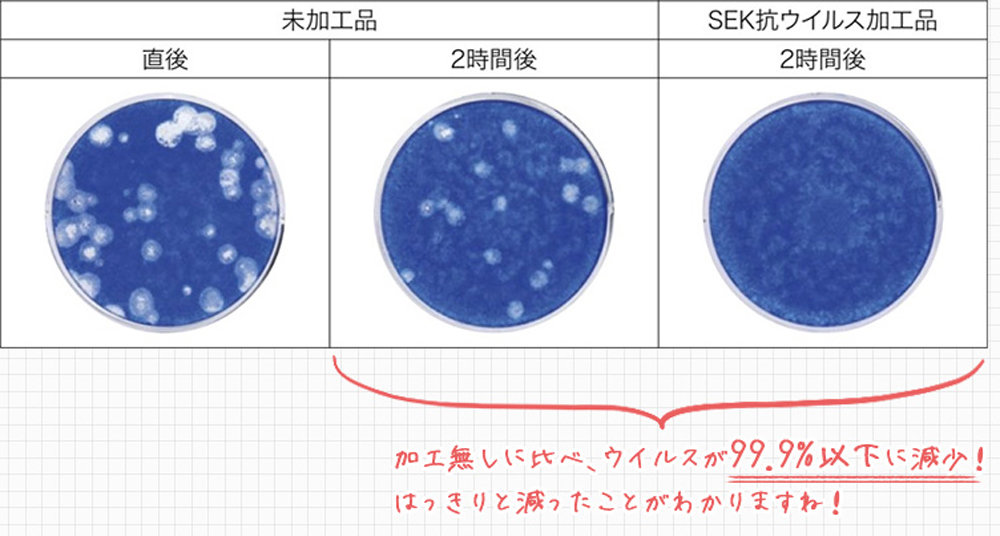
パーフェクトスペース カーテン館 抗菌・抗ウイルス加工レースカーテン～Family guard（ファミリーガード）

DESIGN /
INTERIOR
2020年5月1日
「おうちのマスク」効果を果たすレースカーテンに抗菌・抗ウイルス加工を施した製品が登場|PERFECT SPACE
PERFECT SPACE|パーフェクトスペース カーテン館
室内の換気で気になる細菌・ウイルス付着を99.9パーセントカット
カーテン通販専門ショップのパーフェクトスペース カーテン館が、抗菌加工を施したレースカーテンの取り扱いを開始した。
Text by OZAKI Sayaka|Edit by TSUCHIDA Takashi
窓を開けて換気することが必須の昨今に活躍するレースカーテン
レースカーテンは、室内に取り入れる光を調節しながらプライバシーを守るという機能があるが、窓を開けて換気することを推奨されている今、空気を入れ替えながら外からの花粉やチリ、細菌の侵入を防いでくれる、いわばおうちのマスクのような役割も果たしている。
レースカーテンはマスクと同じく、室外からの細菌侵入を防ぐが、カーテン自体にはたくさんの細菌が付着してしまう……そんな悩みを解決できる「抗菌・抗ウイルス加工レースカーテン~Family guard(ファミリーガード)」が、カーテン通販専門ショップのパーフェクトスペース カーテン館にて、販売開始された。
このカーテンには、繊維上の特定のウイルス(A型インフルエンザウイルス、ネコカリシウイルス)の数を減少させるSEK加工が施されており、この加工をしていない生地と加工済の生地それぞれにウイルスを摂取させ、25度で2時間放置した実験では、ウイルスが99.9パーセント以下に減少していることが実証された。
SEK加工は、繊維評価技術協議会が定めた一定の基準をクリアした製品である証だ。また、防炎、UVカット率60パーセントで、光を適切に取り入れながらの紫外線カットもできる。
抗菌・抗ウイルス加工レースカーテン~Family guard(ファミリーガード) プレーン~
価格|5900円~
価格|5900円~
抗菌・抗ウイルス加工レースカーテン~Family guard(ファミリーガード) ストライプ~
価格|5900円~
価格|5900円~
問い合わせ先
パーフェクトスペース カーテン館 抗菌・抗ウイルス加工レースカーテン
~Family guard(ファミリーガード)
https://www.perfect-space.jp/fs/perfectspace/psr_6443_2h